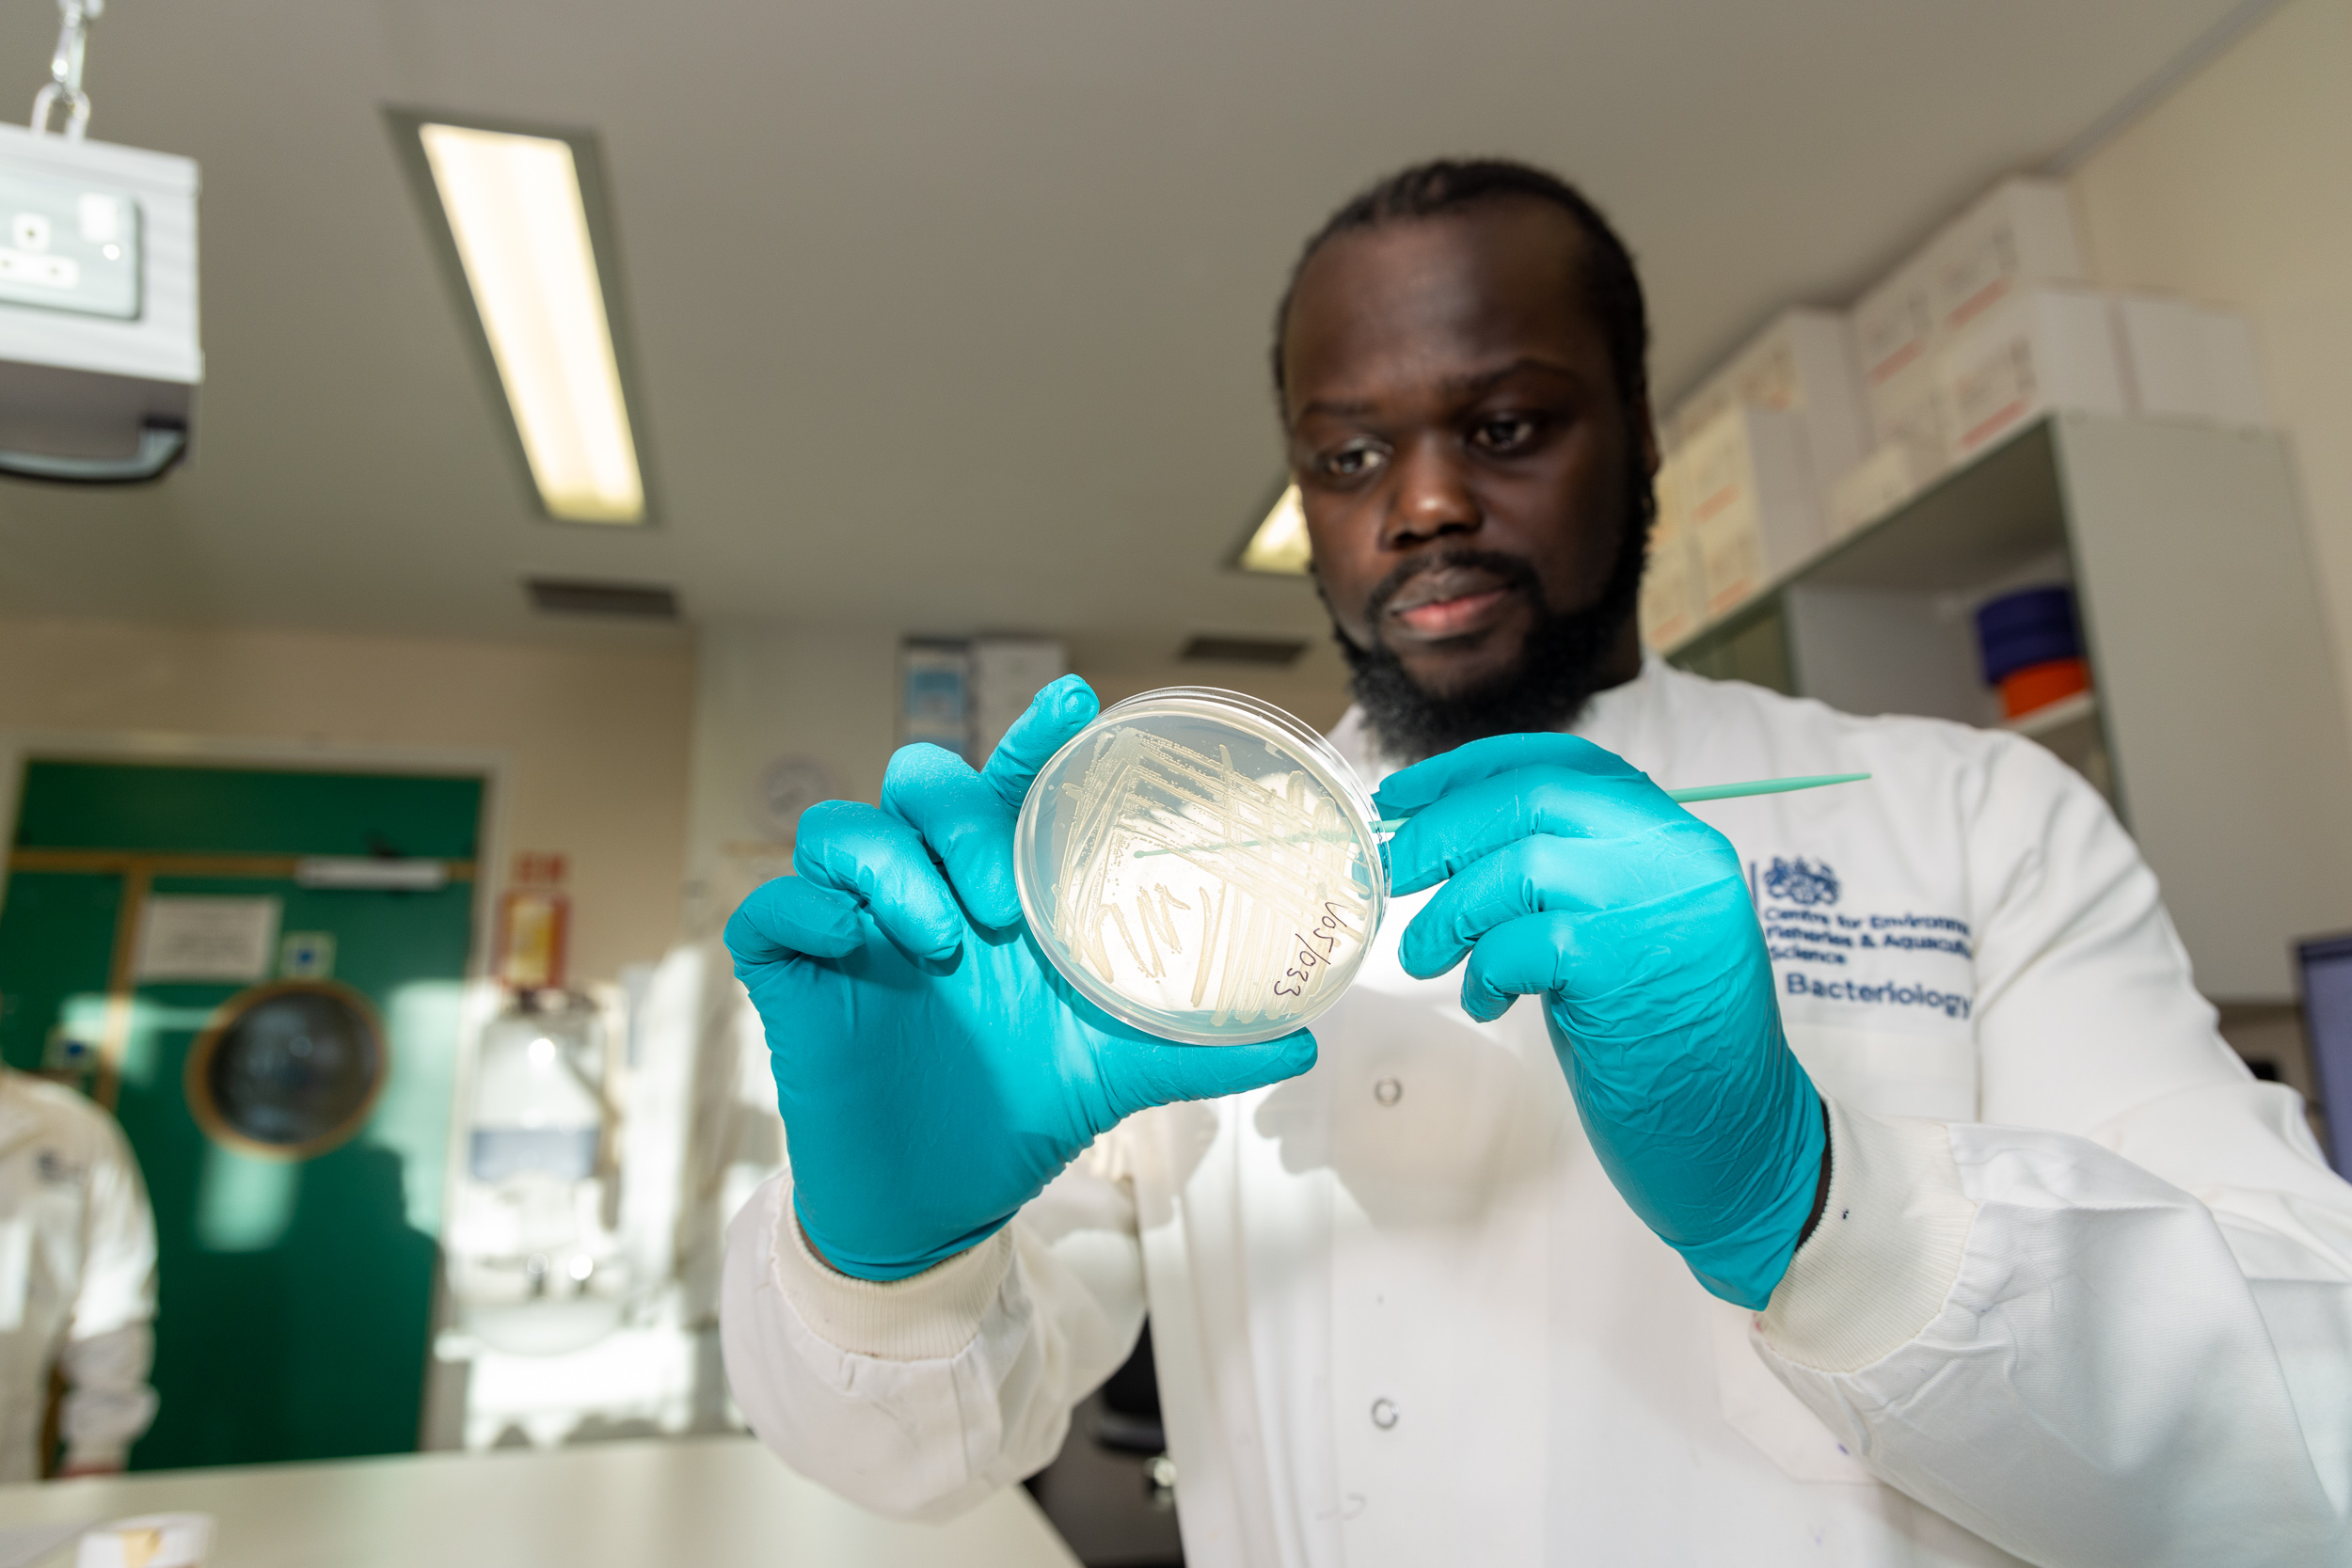
blank
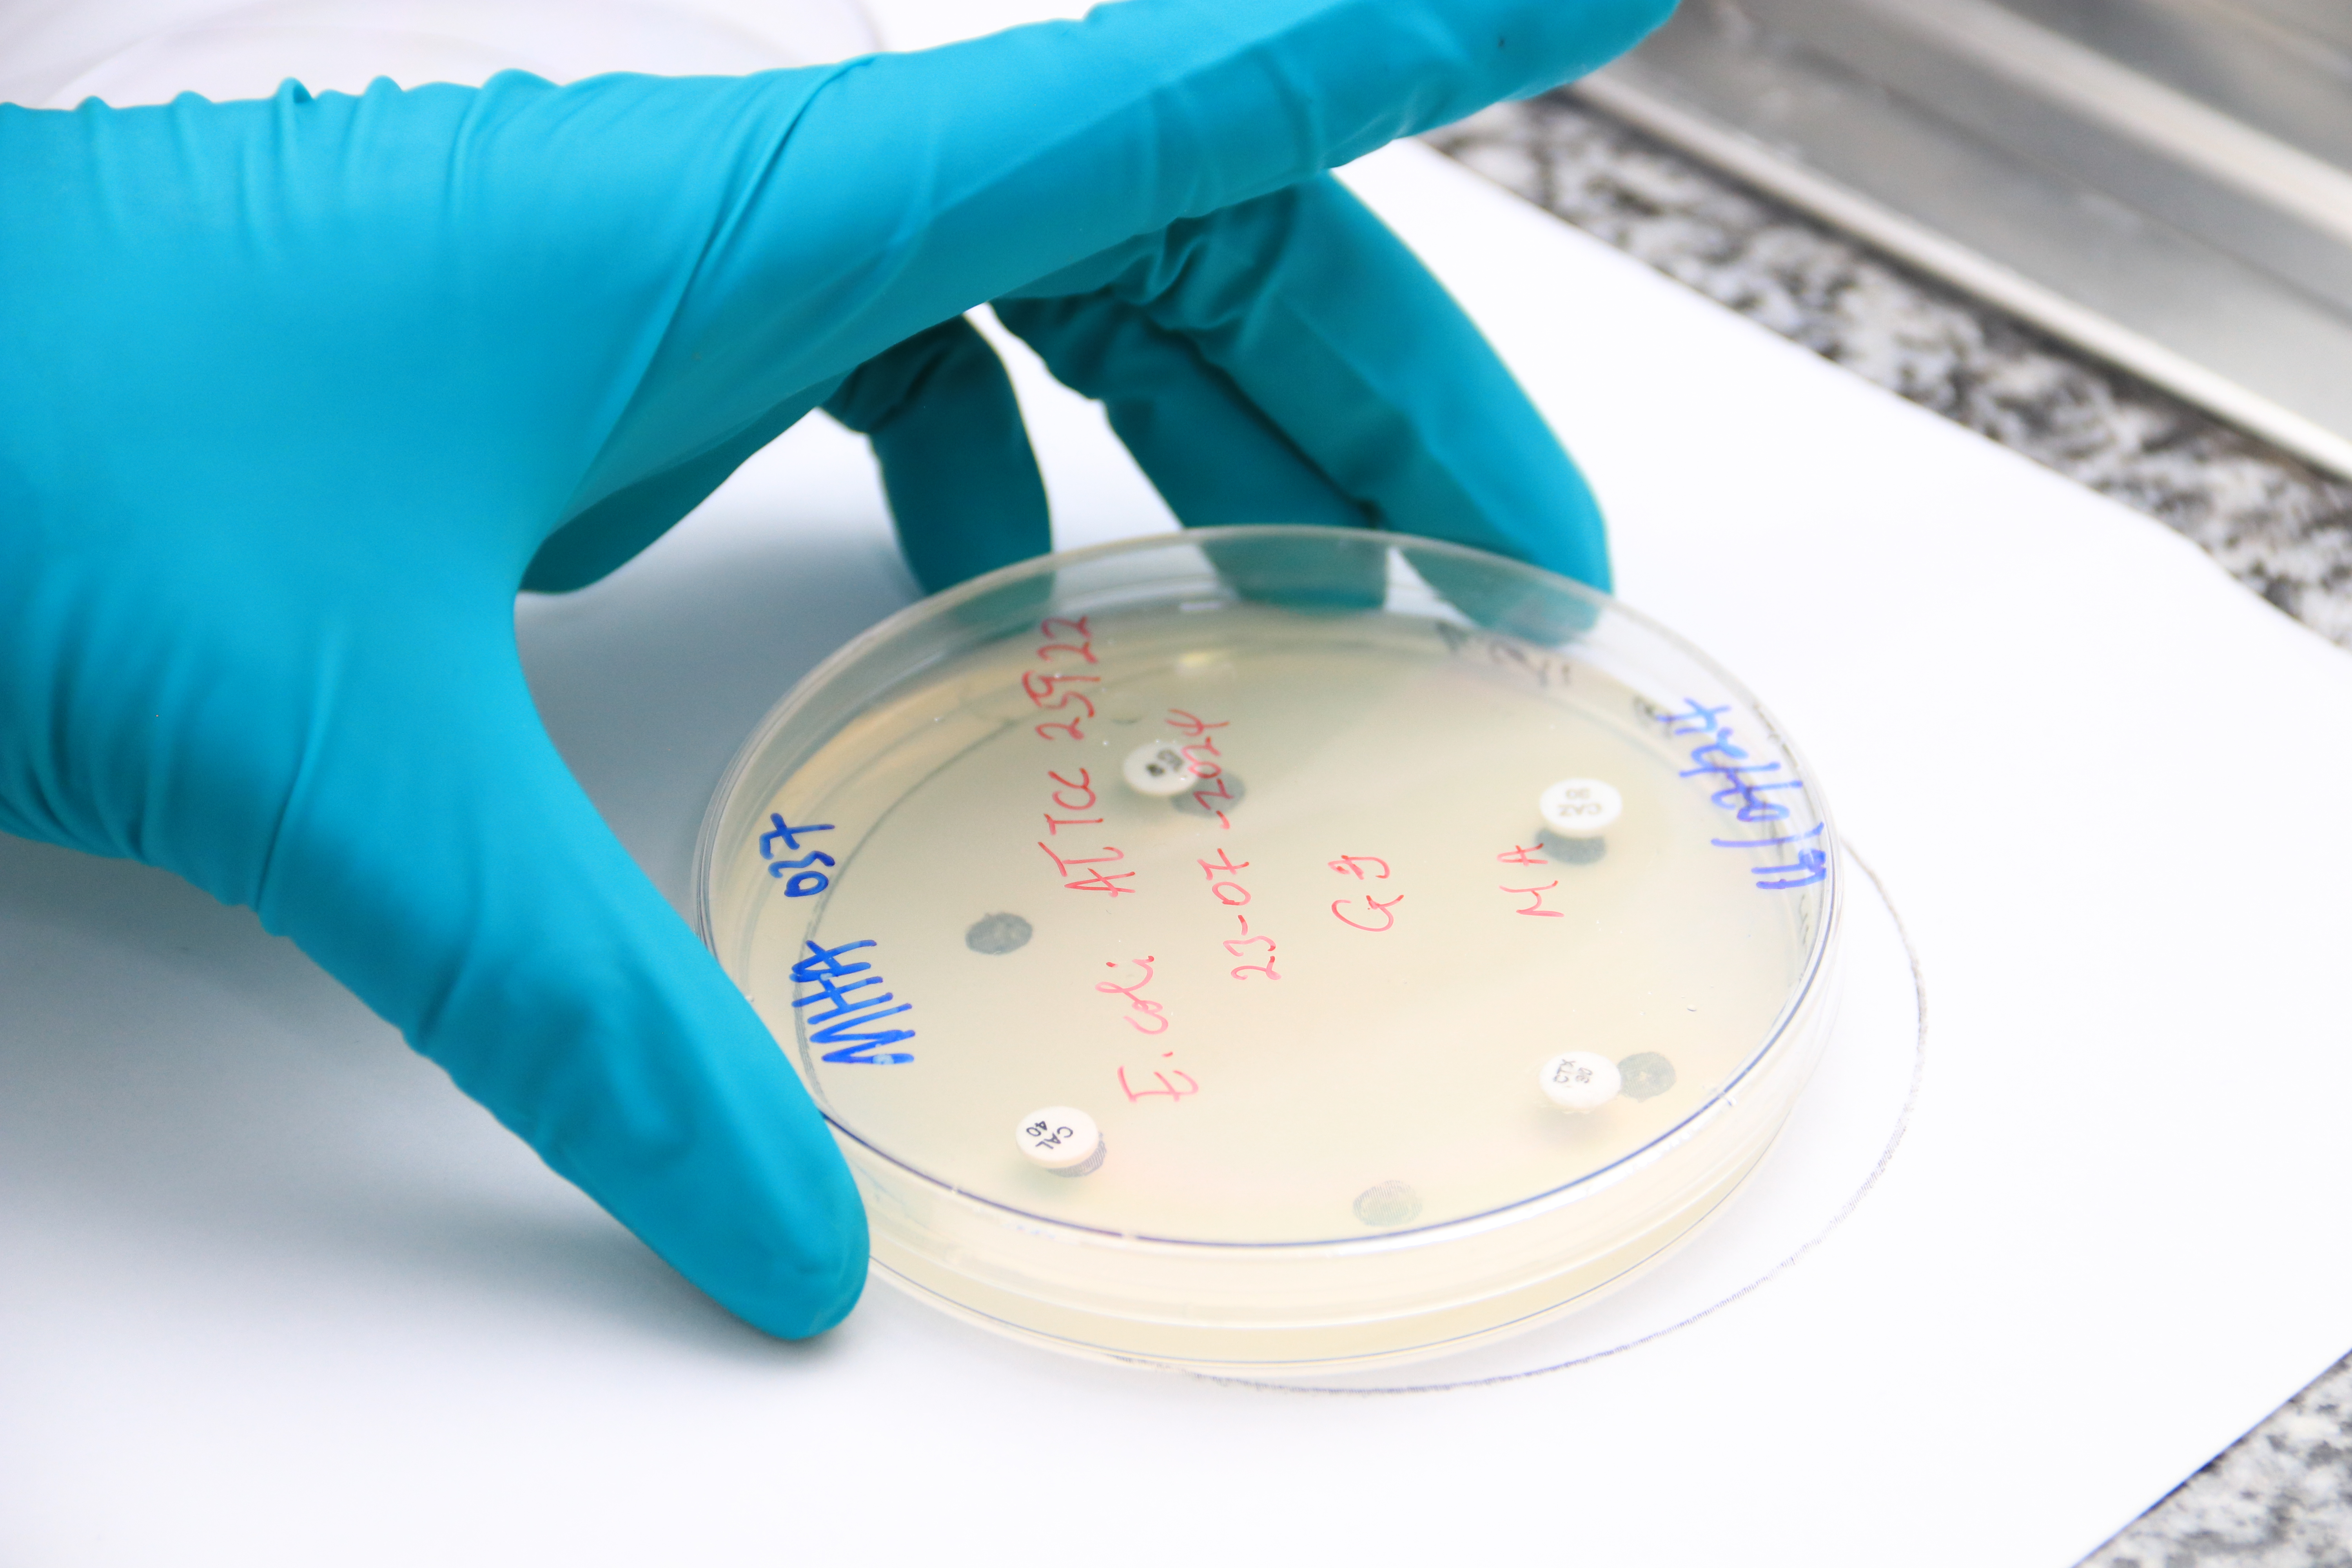
blank

FAO Antimicrobial Resistance (AMR) Reference Centre
Antimicrobial resistance (AMR) is one of the most profound challenges facing humankind. Unless the present rates of increase in AMR are checked, many of the advances in modern medicine will be made redundant and we will return to the pre-antibiotic era, where even a minor cut could result in a life-threatening infection. Antibiotics are also widely used in animal (including aquaculture) production. Thus, erosion in their effectiveness also poses significant food security risks.
AMR is true One Health issue and it is widely recognised that the aquatic environment has a major role in the emergence and dissemination of AMR in both humans and animals. Cefas is uniquely placed to provide advice and initiate research into aquatic AMR issues. We lead cross-cutting research in AMR in relation to aquatic food safety, aquatic animal health and AMR in the wider aquatic environment. This includes our role as partners in the UK’s AMR Reference Laboratory.
Aquatic Animal Health
Cefas is a global leader in aquatic animal health and is positioned to provide services in identifying AMR risks to aquatic animals and to help develop and assess the effectiveness of alternatives to use of antibiotics for control of diseases of farmed aquatic animals (particularly in finfish and shrimp).
For this we are able to draw on our extensive expertise in disease investigation, diagnosis and control, including experience of AMR characterisation of aquatic pathogens. As well as state of the art equipment for measuring AMR, we also have access to a range of advanced pathology and molecular technologies, including high throughput sequencing for pathogen genomics. Our epidemiology and risk teams also have experience in designing and interpreting surveys to help quantify and mitigate ABU on farms.
AMR in the Wider Aquatic Environment
As well as specifically addressing AMR threats associated with farmed aquatic animals and seafood, Cefas also has experience in AMR in the wider aquatic environment. It is increasingly recognised that the aquatic environment acts as an important source and sink for antibiotic resistant bacteria and mobile elements that confer resistance and can readily transfer between bacteria.
Cefas can develop surveillance systems to characterise and quantify AMR in aquatic environments, identify likely hotspots for the emergence of AMR, model AMR transfer between different compartments, assess identified environmental AMR risks to human and animal health and recommend methods to mitigate identified environmental risks.
AMR Reference Lab
Cefas, the UK's Animal Plant Health agency and Veterinary Medicine's Directorate have recently secured funding from the Fleming Fund to establish a UK Reference Centre for Antimicrobial Resistance on behalf of the Food and Agriculture Organisation (FAO). The UK is a global leader in efforts to address the profound challenges AMR presents and the three Defra agencies each play a key role in assisting the UK government in these efforts.
Together, APHA, Cefas and VMD create a powerful and unique synergy of complementary expertise in antimicrobial resistance in bacteria isolated from terrestrial animals, environment and food (APHA); aquatic animals and environment (Cefas); and in monitoring antimicrobial usage (AMU) and development of policy surrounding AMR and AMU (VMD). This expertise will be made available to Low- and Middle-Income Countries (LMICs) prioritised by the Fleming Fund through the AMR Reference Centre.
Our Expertise
- State of the art diagnostic laboratories
- International experts: advise UK Government, FAO and OIE on risks associated with AMR
- Bacterial culture collection
- Capability for high throughput AMR phenotypic testing
- Disc diffusion
- Broth microdilution
- Whole genome sequencing
- AMR genotypic testing
- AMR screening
- Aquatic pathogens
- Environmental samples
- Food safety – shellfish
- Aquarium facility allowing bespoke design for vaccine testing